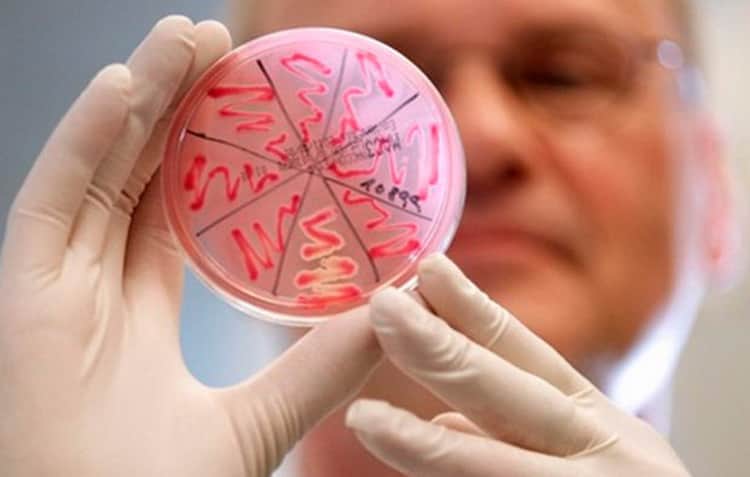

Только при рождении организм малыша начинает заполняться необходимыми микроорганизмами и бактериями, которые в дальнейшем помогают правильно работать всем системам и формируют надежную защиту иммунитета.
Одной из первых заселяется клебсиелла, так как находится практически во всем, что нас окружает. Данная бактерия относится к условно патогенным микроорганизмам, поэтому, когда иммунитет в порядке, то в организме поддерживается оптимальное соотношение полезных и патогенных бактерий.
Однако, любой сбой приводит к тому, что количество патогенных бактерий начинает размножаться и тем самым вызывает определенные нарушения в работе той или иной системы.
Сегодня я предлагаю выяснить, о чем говорит найденная клебсиелла в моче, кишечнике и, соответственно, в кале у грудничка. Давайте разбираться!
Что это такое
Клебсиелла – грамотрицательная палочковидная бактерия. Она способна существовать и размножаться как без доступа кислорода, так и в его присутствии. Она имеет мембрану, которая защищает ее от действия агрессивной среды и антибиотиков. Стоит отметить, что часто при попадании в организм малыша клебсиеллы, родителями не замечаются какие-то нарушения в его жизнедеятельности.
При этом, действительно данная бактерия может достаточно долго существовать в организме маленького человечка, и вы ничего не будете подозревать. В данном случае ни лечить, ни как-то бороться с ней не требуется.
Однако, если иммунитет грудничка ослабевает или происходят другие явления, которые стимулируют ее рост и размножение, то в этом случае требуется немедленное вмешательство врачей.
Давайте узнаем, что может стать причиной инфицирования и, как следствие, появления повышенного количества бактерий в кале ребенка.
Причины появления клебсиеллы в кале малыша
Начать активный процесс размножения и, соответственно, показывать увеличенные показатели в анализах кала или других забранных биоматериалах клебсиелла может по нескольким причинам. Все факторы принято условно объединять в две большие категории: внутренние причины и внешние.
Внешние причины
- Контакт ребенка со взрослым, который является инфицированным.
- Кормление зараженными продуктами.
- Распространение клебсиеллы через грязные игрушки, посуду, животных. Очень важно соблюдать правила гигиены в уходе за ребенком. Ни в коем случае не разрешается трогать грудничка людям, которые пришли с улицы и не помыли руки, не разрешается также давать грязные продукты питания или не помытые после покупки игрушки. Разумеется, не стоит мыть книги и какие-либо бумажные изделия, а вот пластиковые и мягкие игрушки просто необходимо обрабатывать перед тем, как они попадут в руки или в рот к грудничку.
Внутренние причины
- Ослабленный иммунитет.
- Дисбаланс микрофлоры в кишечнике.
- Нехватка полезных бактерий из-за проведенной антибактериальной терапии.
- Наличие других патогенных микроорганизмов в кишечнике, которые могут нарушать здоровую микрофлору.
- Пищевая аллергия у ребенка.
Малыш рождается с очень слабым иммунитетом, поэтому заражение может произойти как во время родов, так и в первое время после них. Для того, чтобы избежать данной неприятности, необходимо во время беременности максимально защищать себя и плод от заражения различными инфекциями, употреблять достаточное количество витаминов и минералов.
Виды клебсиеллезных поражений
В медицине принято выделять 7 видов этой бактерии, однако наиболее часто встречаемыми в анализах кала и опасными для грудничка являются только два вида:
Симптомы болезни у детей до года
Диагностировать заболевание в домашних условиях достаточно тяжело. Нередко симптомы, которые свидетельствуют о наличии клебсиеллы в кале и в целом – в организме малыша, очень схожи с признаками отравления или дисбактериоза, которые являются частыми заболеваниями в жизни новорожденного. Но все же к симптомам клебсиеллы принято относить:
Эти симптомы характерны для группы клебсиелла окситока, что же касается клебсиеллы пневмонии, то тут симптомы очень схожи с признаками гриппа или ОРВИ. К ним можно отнести:
- Резкое повышение температуры до 39, а то и выше градусов.
- Затрудненное дыхание и лихорадка.
- Лающий кашель у ребенка в начале недуга.
- На более поздних этапах появляется кашель с выделениями мокроты, в которой могут отмечаться прожилки крови.
Если вы видите у грудничка хотя бы несколько симптомов, то стоит немедленно обратиться к педиатру. Врач сможет назначить необходимые анализы: исследование кала и других биоматериалов, а также другие обследования на наличие патогенных бактерий в организме крохи.
Чем опасна клебиелла в кале для крохи
В случаях, когда иммунитет грудничка в состоянии побороть атаку и размножение клебсиеллы, то тогда возможно появление лишь инфекционного заболевания, которое лечится в очень короткие сроки и проходит без осложнений. Однако, когда лечение затягивается на долгий период и организм крохи не справляется самостоятельно, то в этом случае возможно появление осложнений:
Диагностика клебсиеллеза
При подозрении у ребенка клебсиеллезной инфекции осмотр проводит врач-гастроэнтеролог или педиатр. Для постановления окончательного диагноза проводится ряд дополнительных исследований. Для этого необходимо сделать забор: кала, мочи, крови, мазка из носовой или ротовой полости, мокроты.
Стоит отметить, что чаще всего врачи диагностируют наличие бактерий клебсиелла пневмония именно в кале, так как она активизируются чаще всего в желудочно-кишечном тракте грудничка.
В очень редких случаях врачи могут обнаружить клебсиеллу в моче. Без наличия каких-либо других симптомов, которые беспокоят грудничка, данное состояние не должно вызывать опасений у родителей и врачей.
Однако, если в то же время у малыша наблюдается повышенная температура, то это может быть признаком ранней стадии пиелонефрита у крохи. В любом случае лечение может быть назначено только тогда, когда диагноз окончательно подтвержден и болезнь сопровождается несколькими симптомами одновременно.
Как лечить клебсиеллу в кале новорожденного
После того как врачи получили результаты анализов, в которых сказано, что у грудничка обнаружена бактерия клебсиелла в кале или в любом другом биоматериале, а кроме того, болезнь сопровождается рядом симптомов, врач обязан подобрать оптимальное лечение данного заболевания. Есть несколько вариантов развития событий:
- Если заболевание было диагностировано на ранних сроках, то назначаются щадящие средства для лечения: синбиотики, бактериофаги, пребиотики. Их задачей является восстановление микрофлоры в кишечнике и, соответственно, организм потом сам сможет справиться с процессом размножения этих бактерий.
- Если же болезнь находится на более поздней стадии или протекает тяжело, то тут никак не обойтись без антибиотиков. Однако, дозировка назначается врачом, исходя из индивидуального состояния здоровья грудничка. Кроме того, прием лекарственных средств также происходит под чутким наблюдением врача. Дополнительно маленькому пациенту могут быть назначены препараты, которые будут вытеснять лишние микроорганизмы из желудочно-кишечного тракта, а также для поднятия иммунитета и восстановления полноценной работы кишечника. На время лечения и восстановительного периода грудничку может быть назначена щадящая диета, которая будет исключать механические и химические раздражители. Если же малыш находится полностью на грудном вскармливании, то корректировке подлежит рацион молодой мамы.
Реабилитация после лечения
После пройденного курса лечения грудничку могут назначить несколько манипуляций для более быстрого восстановления организма. К ним относятся:
- Продолжение приема пробиотиков для восстановления микрофлоры кишечника и налаживания пищеварения.
- ЛФК, витаминные комплексы, закаливание для повышения иммунитета малыша.
- Травяные сборы, которые направлены на восстановление организма и на поднятие иммунитета.
Как избежать клебсиеллеза у ребенка
Если в результатах анализа забранного кала, мочи или другого биоматериала врач увидел незначительное увеличение показателей данной бактерии, то не стоит паниковать. Во всем и всегда придерживайтесь здравого смысла. Если вы начнете лечить болезнь на этом этапе, то вы не дадите возможности организму и иммунной системе крохи «постоять за себя».
Однако в любом случае наиболее правильным вариантом считается выполнение простых правил и манипуляций, которые помогут избежать данного заболевания. К методам профилактики этого заболевания относят:
- Женщины во время беременности не должны пропускать назначенные приемы врача, кроме того, вы должны регулярно сдавать все анализы, которые показывают наличие патогенных бактерий. В случае, если результаты будут положительными, то вы сможете вовремя принять необходимые меры.
- Питание будущей матери должно включать оптимальное количество витаминов, минералов и микроэлементов. Все мы знаем, что пузожителю достается львиная доля всех этих элементов. Именно они влияют на развитие и формирование основных систем в организме малыша.
- Не стоит отказываться от грудного вскармливания. Дело в том, что грудное молоко помогает сформировать сильный иммунитет крохи.
- Родителям всегда стоит помнить о том, что помещение, в котором находится кроха, необходимо всегда поддерживать в чистоте.
- Всегда следите за состоянием здоровья малыша. Всегда обращайте внимание на любые недомогания крохи и старайтесь как можно скорее поднять его на ноги. Кроме того, следите и за рационом грудничка. Он должен быть богатым на витамины и минералы. Таким образом вы сможете построить крепкий иммунитет ребенка.
- Следите за чистотой посуды и предметов, которые окружают его, особенно за теми, с которыми кроха чаще всего контактирует.
- Уделяйте грудничку достаточное количество внимания и прививайте с самого раннего возраста правила личной гигиены.
Все эти рекомендации помогут вам сформировать крепкий иммунитет у малыша и предотвратить вероятность инфицирования маленького крохи.
Видео
Я предлагаю вам посмотреть небольшой видеосюжет, в котором врач-педиатр рассказывает о возможных кишечных инфекциях у ребенка, а также акцентирует внимание на вопросе появления кебсиеллы в кале грудничка. Кроме того, в данном ролике вы узнаете, как правильно лечить и что делать, если у грудничка обнаружили клебсиеллу пневмонии в кале или в других испражнениях малыша.
Кишечные инфекции – это наверное одно из самых распространенных заболеваний, с которым сталкиваются груднички и их родители. В таком возрасте данные заболевания с трудом поддаются диагностике, однако, только правильное и своевременное постановление диагноза и выполненные все рекомендации врача могут привести к хорошему результату.
Человеческий организм населяют миллионы бактерий. Часть из них приносит организму пользу, другие же наносят вред. Но среди всех бактерий можно выделить особую группу – условно-патогенных микроорганизмов, которые до определенного момента спокойно существуют в организме и их жизнедеятельность никак не влияет на работу органов и систем. Клебсиелла – одна из таких бактерий. Клебсиелла часто обнаруживается у новорожденных, но и у взрослых людей это тоже не редкость. Сегодня я расскажу вам о том, что означает, если диагностирована клебсиелла пневмония в кале у ребенка.
Клебсиелла (клебсиеллезная инфекция)
В мире достаточно распространенными являются заболевания, вызванные условно-патогенными микроорганизмами, среди которых клебсиелла занимает ведущее место. В зависимости от состояния иммунной системы человека этот возбудитель может явиться причиной как легкого инфекционного заболевания, так и тяжелого септического проявления.
Микробиологически это грамотрицательные палочки (при окраске по Грамму не имеют специфического фиолетового окрашивания) небольшого размера (1,0*6,0 мкм), неподвижные, располагаются как попарно, так и в одиночку, а также цепочками.
Клебсиелла (Klebsiella) – условно-патогенный микроорганизм, который является представителем семейства Enterobacteriaceae. Название получила от фамилии немецкого ученого, бактериолога и патологоанатома ее открывшего – Эдвина Клебса.
Являются факультативными анаэробами (способны размножаться в отсутствие кислорода, однако при его наличие не теряют своей жизнестойкости). Клебсиеллы способны образовывать капсулу, благодаря которой устойчивы в окружающей среде. Имеют О-антигены (около 11) и К-антигены (около 70), по которым отличаются внутри рода.
Виды клебсиелл
Klebsiella pneumoniae (палочка Фридлендера), Klebsiella oxytoca, Кlebsiella rhinoscleromatis (палочка Фриша-Волковича), Klebsiella ozaenae (палочка Абеля-Лавенберга), Klebsiella terrigena, Klebsiella planticola. Наиболее частые возбудители заболеваний человека – это K. pneumoniae (ответственны за поражение легочной ткани) и K. oxytoca (вызывает поражение кишечника).
Также при воздействии различных видов клебсиелл у ослабленных лиц, новорожденных и грудных детей могут возникать поражения носа и верхних дыхательных путей, глаз (конъюктивиты), менингиты, сепсис, поражение мочеполовой системы.
В нормальных физиологических условиях клебсиелла является представителем нормальной флоры пищеварительной системы (кишечника), чаще это K. pneumoniae. В норме содержание клебсиеллы в 1 гр испражнений не должно превышать 105 микробных клеток.
Клебсиеллы также присутствует на коже, слизистой оболочке дыхательных путей человека и теплокровных животных. Клебсиелла сохраняет свою жизнеспособность в почве, воде, пыли, пищевых продуктах (может размножаться в молочных продуктах в холодильнике). Клебсиеллез является довольно частым проявлением внутрибольничной инфекции.
Клебсиелла в гастроэнтерологии ( Klebsiella pneumoniae)
Клебсиелла может стать причиной острого гастрита — острого воспаление слизистой оболочки желудка, возникающего по причине воздействия инфекционного фактора непосредственно на слизистую оболочку желудка. Обычно это связано с употреблением недоброкачественной пищи, неправильным хранением смесей и продуктов, несоблюдением гигиенических правил.
Клебсиелла (в основном Klebsiella pneumoniae, но также встречаются Klebsiella oxytoca, Klebsiella aerogenes и другие) является представителем нормальной микрофлоры кишечника человека. В то же время, клебсиелла может вызывать ряд гастроэнтерологических заболеваний.
Клебсиелла может начитать интенсивно развиваться, вызывая патологический процесс в желудочно-кишечном тракте, в частности, после терапии антибактериальными препаратами, побочным действием которых является подавление основных представителей нормальной микрофлоры желудочно-кишечного тракта (бифидобактерий и других), тормозящих чрезмерный рост клебсиелл.
Источниками возбудителя инфекции являются больной человек и бактерионоситель. Наиболее частые пути передачи — пищевой, воздушно-капельный и контактно-бытовой. Передача происходит также через загрязненные пищевые продукты, особенно часто через мясные и молочные. Клебсиеллез является одной из распространенных внутрибольничных инфекций.
Причины заболевания клебсиеллой
Соблюдение правил гигиены обязательно не только для самого ребенка, но и для взрослых. Мытье рук после посещения туалета и возвращения с улицы, стерилизация детских сосок и бутылочек, ограждение ребенка от пользования грязными вещами – выполнение этих и других условий обязательно должно контролироваться родителями.
Кроме этого, заниматься поддержанием и укреплением иммунитета необходимо с самого рождения малыша. Для этого маме необходимо максимально долго кормить ребенка грудным молоком. Можно давать малышу общеукрепляющие капли, содержащие прополис, мед или другие натуральные иммуностимуляторы (по согласованию с врачом).
Диагностика келбсиеллы пневмании в кале у ребенка
Для уточнения состояния других органов пищеварительной системы может назначаться УЗИ, фиброгастродуоденоскопия, дуоденальное зондирование.
Для подтверждения диагноза используются лабораторные методы:
- бактериологическое исследование кала: дает возможность определить виды микроорганизмов, их количество и чувствительность к антибиотикам и бактериофагам; для анализа необходимо примерно 10 г утренней порции испражнений, собранных в стерильную емкость и доставленных сразу же в лабораторию;
- клинический анализ кала (копрограмма): исследование перевариваемости пищи в кишечнике.
Симптомы клебсиеллы пневмании у ребенка
Часто дисбактериоз у грудных детей начинается из-за того, что в определенный момент в организме ребенка начинает активно размножаться клебсиелла. Эта бактерия, заполняя просвет кишечника, разрушает его микрофлору.
Негативное влияние клебсиеллы начинается не сразу, а через некоторое время после начала размножения. Именно поэтому заранее догадаться о ее наличии и предотвратить последствия невозможно. Симптомы клебсиеллы у детей схожи с симптомами дисбактериоза.
Чаще всего появляются нарушения со стороны пищеварительного тракта. У ребенка снижается аппетит, беспокоит чувство вздутия живота. Могут возникать ноющие, тянущие боли в животе, более выраженные во второй половине дня. Они могут иметь схваткообразный характер. У малышей грудного возраста отмечаются срыгивания (или рвота), снижение веса тела.
Дети старшего возраста могут отмечать неприятный металлический привкус во рту. Характерным является чередование поносов и запоров. Стул имеет неприятный запах, в каловых массах может появляться примесь слизи и непереваренной пищи.
Появляются частые позывы к акту дефекации – так называемый «симптом утки» или «проскальзывания пищи»: только приняв пищу, ребенок садится на горшок или бежит в туалет. Стул при этом может быть водянистым, слизистым, с непереваренными остатками пищи.
Нередко развиваются аллергические реакции в виде различного рода высыпаний, дерматитов, шелушений кожи. Развивающийся при дисбактериозе дефицит витаминов проявляется кровоточивостью десен, ломкостью ногтей и волос.
Меняется и поведение ребенка: он становится капризным, беспокойным, плаксивым, плохо спит. При далеко зашедшем дисбактериозе может повышаться температура в пределах 37,5 . Клебсиелла является одним из возбудителей кишечных инфекций, а также пневмонии в детском возрасте. Заражение происходит через пищу и воду.
Общие симптомы заражения клебсиеллой:
- диарея, жидкий стул с примесью слизи;
- боли в животе; ребенок беспокоен, не прибавляет в вес;
- в бактериологическом анализе кала выявляется соответствующий тип клебсиеллы.
Симптомы клебсиеллы у грудничка
Клебсиелла относится к условно-патогенным микроорганизмам, поскольку присутствует в организме человека постоянно. Эти бактерии — рекордсмены по частоте возбуждаемых ими кишечных инфекций.
Главное клиническое отличие клебсиеллы от стафилококка — цвет кала. Если при стафилококковой инфекции кал светло-желтый, то при поражении клебсиеллой он темно-зеленый. Для клебсиеллы также характерно более активное газообразование.
Клебсиелла в целом характеризуется тем же симптоматическим комплексом. Однако в отличие от золотистого стафилококка бактерия менее агрессивна и поражает преимущественно детей с ослабленным иммунитетом, дисбактериозом или имеющейся стафилококковой инфекцией.
Причин инфицирования несколько:
- взрослые нередко пренебрегают правилами личной гигиены и санации предметов обихода. Клебсиелла обычно попадает в организм ребенка именно после контакта с руками взрослого носителя или грязными предметами;
- часто клебсиелла инфицирует грудничков в процессе взаимодействия с общественными игрушками в поликлиниках и больницах;
- контакт с грязной пустышкой. Если пустышка падает на пеленальный стол или на пол, родители часто обтирают (а иногда и обсасывают) предмет и помещают его обратно в рот ребенку. Это прямой путь к инфицированию.
Симптомы клебсиеллы (клебсиеллёза) в ЖКТ у грудничков
Симптомы клебсиеллы у малышей схожи с симптомами дисбактериоза: вздутие, метеоризм, колики, срыгивание. Но чаще проявляются — жидким стулом со слизью, кровью и резким запахом, повышением температуры, лихорадкой, болями в животе и сильным обезвоживанием организма.
В зависимости от того, какой иммунитет у малыша, течение заболевания может протекать как в лёгкой форме, так и грозить тяжелыми инфекционными осложнениями. Если клебсиелла в организме быстро размножается, выделяет токсины, нарастает интоксикация, обезвоживание, то заболевание может проявиться в течение нескольких часов и потребует срочной госпитализации ребенка.
Поэтому, при любом расстройстве стула, необходимо обратиться к врачу, сдать кал ребёнка на анализ, пройти обследование, чтобы точно выявить, какие именно бактерии вызвали изменение состояния ребёнка. Большую роль в восстановлении иммунитета и нормальной микрофлоры у новорожденного играет грудное вскармливание.
При высокой обсеменённости клебсиеллой и тяжёлой форме заболевания, лечении ребенка в больнице, назначают сложную терапию с применением антибиотиков. Если заболевание грудничка протекает в лёгкой форме, то для коррекции микрофлоры кишечника назначают пробиотики.
Ребенок может чувствовать себя нормально, а при обследовании находят в анализах повышение количества клебсиелл. Тогда препараты с лакто- и бифидобактериями назначают для вытеснения излишнего количества клебсиеллы, повышения иммунитета, улучшения собственной полезной микрофлоры.
Как сделать анализ кала при клебсиелле ребенку
Перед тем как собрать кал, мама должна тщательно вымыть руки и подготовить стерильную посуду. Для транспортировки подобных анализов в аптеках продают специальные стерильные баночки. На обратной стороне пластиковой крышки закреплена удобная лопатка, с помощью которой легко набирать порции материала.
Следует знать, что для анализа годится средняя часть кала. Из нее в трех разных точках набираются пробы, которые оставляют на стенках баночки не смешивая. Замораживать кал нельзя. Взятая на анализ проба не должна соприкасаться с другими жидкостями или материалами: пеленками, памперсом, мылом, влажными салфетками и т.д.
В БАК-лаборатории пробу поставят в специальный шкаф, предварительно поместив в питательную среду. Здесь образец пробудет около 10 суток. В течение этого времени в питательной среде начнут размножаться те виды бактерий, которые присутствуют в кишечнике ребенка.
В результате анализа лаборант определит количественные показатели, по которым можно судить о том, каких колоний микроорганизмов в кишечнике больше. Существуют нормированные значения, определенные для каждого типа бактерий. Пользуясь ими, врач определяет тяжесть заболевания.
Для детей, которым еще нет 1 года, количество колоний клебсиеллы в 1 г материала не должно превышать 105. В зависимости от того, насколько превышено это значение и от силы проявления симптомов врач диагностирует степень тяжести клебсиллеза.
Норма анализа кала на клебсиеллу у ребенка
Количество клебсиелл в кале подсчитывают при анализе на дисбактериоз. Обычно это вид клебсиелла пневмонии. Норма — не более 10 5 клебсиелл на 1 г кала. Наличие клебсиелл в кишечнике далеко не всегда требует противомикробной терапии.
По данным лабораторной службы Хеликс, референсными значениями содержания клебсиелл в кале при микробиологическом исследовании кала, как для пациентов до года, так и для пациентов старше года, являются: Klebsiella pneumoniaе — менее 10 4; Klebsiella oxytoca — менее 10 4; Klebsiella aerogenes — менее 10 4.
Как лечить клебсиеллу у ребенка
Если педиатр диагностировал клебсиллез легкой или средней формы, лечение будут сведено к употреблению поливалентного клебсиллезного бактериофага. В состав этого препарата входят особые микроорганизмы – бактериофаги.
Их особенность и польза состоит в том, что они воздействуют только на клетки клебсиеллы, не оказывая влияния на слизистую кишечника и прочую микрофлору. Фаги обволакивают клетки клебсиеллы и, уничтожая бактерии, используют их для собственного размножения. Побочных действий бактериофаг не имеет.
Лечение заболевания происходит в три этапа. Каждый из них занимает пять дней. В течение первого и третьего грудничку дважды в день за 20 минут до кормления дается 5 мл бактериофага, нагретого до комнатной температуры.
На ночь малышу делается клизма с тем же препаратом. 10 мл неразведенного бактериофага, вводится в кишечник ребенка и выдерживается в течение 10-15минут. В течение этого времени лекарство всасывается в слизистой кишечника, одновременно воздействуя на клебсиеллу. Между двумя периодами лечения делают небольшой перерыв (обычно 5 дней).
Пока идет лечение, врач может назначить курс пробиотиков. Ребенку их нужно будет давать в течение двух недель. Эффект от лечения бактериофагом заметен уже на вторые сутки. Колики становятся менее интенсивными и болезненными, ребенок лучше и спокойнее спит, активнее ест.
При тяжелом течении заболевания бактериофаг бесполезен, поэтому ребенку назначаются антибиотики. Одновременно малышу нужно будет оказать поддержку в виде витаминов, пробиотиков и иммуностимулирующих препаратов.
Это так называемые естественные пробиотики, наиболее часто используемые при клибсиелле и являющиеся хорошей альтернативой лекарствам:
- Бифидок: представляет собой кефир с добавлением Бифидумбактерина: восстанавливает нормальную флору в кишечнике, способствует подавлению гнилостных и условно патогенных бактерий, замедлению роста стафилококка;
- Бифилин: может применяться с самого рождения младенца, содержит бифидобактерии, может применяться и во время лечения антибиотиками; восстанавливает микрофлору кишечника;
- Иммунеле: содержит большое количество лактобактерий и витаминов; нормализует микрофлору, повышает иммунитет;
- Активия: содержит бифидобактерии, но может применяться только с 3-летнего возраста ребенка;
- Актимель: содержит лактобактерии, тоже способствует восстановлению микрофлоры кишечника.
Последствия клебсиллеза для ребенка
Если заболевание протекало в легкой форме и было вылечено с помощью бактериофагов, то последствий для малыша не будет никаких. Кишечник полностью восстанавливается и продолжает нормально работать.
Если клебсиллез протекал тяжело, в качестве осложнений могут проявиться:
- конъюнктивит; насморк, который может перейти в гайморит;
- инфекционные заболевания кишечника; воспаление легких;
- менингит.
Такие сложные последствия могут наступить только в том случае, если организм ребенка был сильно ослаблен или истощен. Именно поэтому родители должны серьезно взяться за укрепление детского здоровья.
Профилактика клебсиеллы у ребенка
Неспецифическая профилактика (вакцина) не разработана.
Профилактические мероприятия сводятся к гигиеническому воспитанию детей, укреплению иммунитета, своевременному лечению хронических заболеваний и инфекций.
Что делать если высеивается клебсиелла в кале у грудничка? Насколько клебсиелла опасна для здоровья грудничка, и что делать в первую очередь? Что должно насторожить в состоянии ребенка, и когда необходима госпитализация? Эти вопросы довольно часто возникают среди новоиспеченных мам.
Что такое бактерия клебсиелла?
Клебсиелла – это условно-патогенная бактерия, относится к семейству Enterobacteriaceae. Заражение проходит через воду, землю, необработанные фрукты и овощи. Клебсиелла обитает в кишечнике или органах дыхания человека и может совершенно себя не проявлять.
В начале 2017 года, клебсиелла была внесена Всемирной организацией здравоохранения к самым опасным бактериям, этому есть несколько объяснений: высокая устойчивость к антибиотикам и тяжелые осложнения в случае болезни.
Причины возникновения опасной бактерии в кале у ребенка
Взрослый человек с сильным иммунитетом вряд ли заболеет данным недугом. Зачастую жертвами становятся или новорожденные, или пожилые люди.
Приходя в этот мир, маленький человечек встречается с массой микроорганизмов. Если беременность доношенная, протекала без осложнений и роды прошли успешно – вероятность возникновения этой инфекции у грудничка очень мала.
Но если на первых порах жизни возникли проблемы у грудничка, клебсиелла может появиться.
Причины почему возникает клебсиелла у грудничков:
- Рождение раньше срока и необходимость длительного пребывания новорожденного в стенах роддома, где нередко случаются нарушения санитарно-гигиенических норм;
- Несоблюдение гигиенических правил при уходе за малышом – грязные руки, необработанные игрушки и бутылки, домашние животные;
- Маловесные дети. Считается, что новорожденные с весом меньше 2 кг имеют ослабленный иммунитет и более подвержены различным инфекциям.
- Рождение через кесарево сечение. Хирургическое вмешательство нарушает естественный процесс родоразрешения и передачу полезной микрофлоры от мамы ребенку.
- Прием антибиотиков. Данные препараты негативно влияют на работу желудочно-кишечного тракта и могут повлечь присоединение вредных бактерий.
- Аллергические реакции в организме малыша также провоцируют размножение различных вредных микроорганизмов.
- Если мать кормит ребенка грудью, а сама не соблюдает диету или злоупотребляет вредными привычками. Такое отношение, влечет недостаток питательных веществ и витаминов в маленьком организме.
Признаки и симптомы заболевания у малышей
Если клебсиелла высеялась в кале у грудничка, но ребенок чувствует себя отлично – это еще не повод срочной госпитализации и приема массы лекарств.
Нужно обратить особое внимание на признаки и симптомы, при появлении которых незамедлительно лечиться:
- частая рвота;
- одышка и глубокий кашель;
- беспокойство и нарушение аппетита;
- диарея;
- высокая температура тела;
- бледность и синяки под глазами.
При поражении носоглотки могут выделяться гнойные выделения с неприятным запахом.
Виды клебсиеллезных поражений
Существуют следующие виды клебсиеллезных поражений:
- Клебсиеллезная пневмония;
- Клебсиелла желудочно-кишечного тракта;
- Сепсис;
- Инфецирование мочеполовой системы;
- Клебсиелла мозговых оболочек;
- Клебсиеллезный коньюктивит;
- Поражение суставов и костей.
Диагностика заболевания
Для удачного диагностирования необходима консультация инфекциониста, педиатра и гастроэнтеролога.
Поэтому при первичном осмотре педиатр назначает сдать общий анализ крови и мочи, бактериологический посев испражнений, гнойной мокроты или рвотных масс. Параллельно проводится анализ на восприимчивость к антибиотикам.
Гастроэнтеролог может назначить ультразвуковое исследование организма, в частности, печени, ЖКТ, почек и селезенки.
Клебсиелла окситока у грудничка
Клебсиела окситока – это наиболее распространенный подвид бактерии, который обосновывается в кишечнике. При нормальном иммунитете клебсиелла не доставляет каких-либо трудностей человеку.
Симптомы у грудничка:
- Расстройство кишечника. Характерен водянистый кал зеленоватого цвета с непереваренными частицами еды;
- Многократные срыгивания или рвота. В первые дни заболевания количество рвотных позывов может доходить до 10;
- Колики и повышенное газообразование;
- Повышенная температура тела до пяти дней;
- Слизь в кале. В тяжелых случаях могут быть кровянисты сгустки;
- Боли в животе;
- Беспрерывный плач;
- Отказ от еды.
Клебсиеллезная пневмония – палочка Фридлендера
Является возбудителем бактериальной пневмонии, гнойных гайморитов, абсцессов печени и инфекций мочеполовой системы. Считается больничной инфекцией, и зачастую люди заражаются ею в стационарах. Обнаруживается в моче, в кале и мокроте.
Симптоматику можно спутать с простудным заболеванием или любой другой бактериальной пневмонией:
- Повышение температуры до 39 градусов, а может быть и выше;
- Ребенка знобит или наблюдается повышенная потливость;
- У грудничка начинается глубокий кашель с кровохарканьем;
- Насморк на начальной стадии, далее развивается гнойный гайморит;
- Ребенку в положении лежа трудно дышать, наблюдается одышка.
Врачи рекомендуют Монастырский чай из природных компонентов для профилактики и лечения болезней пищеварительной системы . В его состав входит только натуральные травы с приятным ароматом. Можно употреблять вместо обычного чая ! Более подробная информация здесь.
Внимание! Это сертифицированный, протестированный продукт с доказанной эффективностью!
Если страдает мочеполовая система, возможно:
- Ощущение жжения в момент мочеиспускания;
- Болевые ощущения в пояснице.
Лечение клебсиеллы
Выбранный курс лечения назначает педиатр в зависимости от состояния больного и его анализов. При обнаружении кишечной инфекции в легкой форме, то есть, данные в результатах незначительно превышают норму – назначаются бактериофаги, ферменты и пробиотики.
- Если у грудничка клебсиелла и наблюдается тяжелое состояние — обильная рвота и частый водянистый стул – это уже повод лечь в стационар. Дети такого возраста крайне подвержены обезвоживанию, в тяжелый случаях возможен даже летальный исход.
- Рекомендуется обильное питье и этиотропная терапия, то есть в стационаре берутся все анализы и на время их обработки врач прописывает антибиотики широкого спектра.
- Когда исследования готовы и высеивается клебсиелла, лечащий доктор выписывает антибиотики специфического действия. Зачастую пенициллины, аминогликазиды, цефалоспорины, тетрациклины.
- Бывает клабсиелла обнаруживается в кале в содружестве со стафилококком – это приводит молодых родителей в шок. Специалисты успокаивают и обосновывают тем, что опасность ситуации напрямую зависит от состояния ребенка. Насколько его организм готов бороться с такими бактериями? Если чадо не имеет вышеперечисленных симптомов угрожающих жизни, стоит повременить с сильнодействующими препаратами и остановиться на бактериофагах.
- В борьбе с клебсиеллой хорошие отзывы получил препарат Энтерофурил, противомикробный препарат широкого действия. Его эффективность доказана в отношении таких бактерий, как Клебсиелла, Сальмонела, Стафилокок и Стрептокок.
- К вышеперечисленным лекарствам дополнительно назначают пробиотики — Линекс, Биовестин, Бифиформ. Если препараты подобраны правильно, ребенок уже через пару дней начнет чувствовать себя лучше. Лечение длится от 10 до 21 дней.
Реабилитация после лечения
Перенесенная клебсиелла и применение синтетических препаратов негативно влияют на жизнедеятельность малыша – он теряет вес, ослабевает иммунная защита, возможна физическая слабость.
Именно поэтому многие специалисты советуют проводить оздоровительные процедуры, такие как лечебная физкультура, массаж, длительное пребывание на свежем воздухе, прием витаминов.
С целью восстановления микрофлоры кишечника у грудничка, педиатр может продлить курс пробиотиков. Также существует практика приема травяных сборов.
Последствия заражения
Запоздалое диагностирование и лечение может привести к тяжелым последствиям для здоровья малыша. На первых порах существования новорожденного, ему жизненно важно набирать вес и потеря даже 500 грамм может крайне негативно отразиться на его самочувствии.
Если диагностирование было проведено не вовремя, и клебсиелла была обнаружена в запущенной форме — это может привести к таким тяжелым заболеваниям:
- гнойный менингит;
- токсический гепатит;
- некроз тканей;
- энцефалит и другие.
Видео: кишечная палочка у грудничка — доктор Комаровский
Как избежать клебсиеллеза у ребенка?
Меры профилактики включают укрепление иммунитета и общего и местного, соблюдение санитарно-гигиенических норм при уходе за малышом, лечение хронических заболеваний, соблюдение противоэпидемического режима в период обострения простудных заболеваний в обществе.
По возможности избегать больничных помещений и стационаров. Вопрос о том, чтобы проведать больного родственника в стенах больницы, вообще, не должен стоять.
Из вышеприведенной информации ясно, что клебсиелла обрушивается на слабый организм, особенно подвержены недоношенные и маловесные новорожденные.
Выбор метода лечения полностью зависит от того, как себя чувствует малыш – если он активен и требует еду, значит, организм готов сам бороться.
Важным фактором в преодолении инфекции с минимальным вредом для организма является временное диагностирование и правильный подбор препаратов. Сегодняшний уровень медицины позволяет не доводить ситуацию до осложнений и предотвратить все ужасы, которые может нанести клебсиелла на организм грудничка.